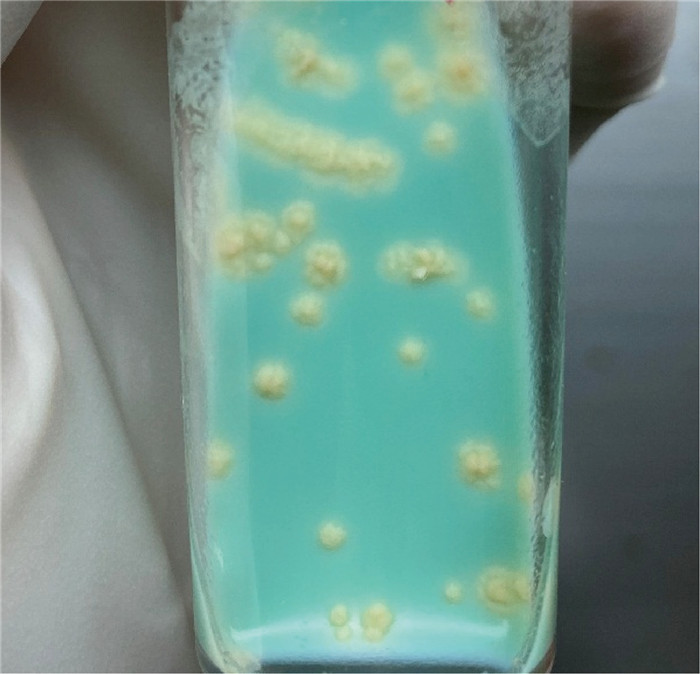

TBM可导致半数患者致残或死亡,已引起全球公共卫生的广泛关注[1-2]。尽可能在TBM的早期明确诊断在全球范围内仍是一项严峻挑战,尤其在资源有限地区,其高误诊率与治疗延误直接导致患者预后不良。尽管分子诊断技术显著提升了检测灵敏度,但其高昂成本及对实验室条件的要求限制了广泛应用。此外,TBM患者常合并HIV感染或免疫抑制状态,进一步干扰传统检测方法的可靠性。本病例通过整合快速涂片镜检、分子检测及培养技术,不仅验证了阶梯式诊断策略的可行性,也为优化诊断资源配置提供了实践参考。
1 病例资料患者男,24岁,因“发现意识淡漠、发热半天”于2022年3月24日18:05就诊于深圳大学总医院(简称“该院”)急诊科。患者因未按期行新型冠状病毒核酸检测,社区服务人员上门检查发现患者意识淡漠,有发热,最高体温38.5 ℃,未诉肢体抽搐、呕吐等,遂联系110及120,后接入我院。患者出现发热时间不详,体温最高38.5 ℃,伴谵妄,伴咳嗽、咳痰无力,大小便失禁。完善相关检查,新型冠状病毒核酸检测阴性,考虑病情较重,遂以“发热待查”收入该院ICU。
诊疗过程如下。3月24日,患者到院后查血常规示白细胞计数20.62×109/L↑,中性粒细胞百分比93.1%↑;C反应蛋白23.86 mg/L↑;降钙素原0.488 ng/mL↑;脑脊液测压大于320 mmH2O。脑脊液常规示白细胞335.2×106/L↑,潘氏试验2+;脑脊液生化示氯108.0 mmoL/L↓,葡萄糖 < 1.11 mmoL/L↓,脑脊液蛋白4 056.97 mg/L↑。头胸计算机断层扫描(computed tomography, CT)提示:1.考虑双肺弥漫性细支气管炎;左肺上叶尖后段、右肺下叶背段薄壁空洞,真菌性感染待排,请结合临床;2.脑室系统扩张,右侧顶叶皮层下片状低密度灶;3.左肺上叶散在钙化灶(见图 1~2)。3月25日晨经验用药予哌拉西林/他唑巴坦4.5 g q8h和莫西沙星0.4 g qd,16: 56脑脊液涂片结果显示:抗酸+ +(抗酸染色结果如图 3)。根据抗酸染色结果,临床医师立即予异烟肼片600 mg qd,利福平0.6 g qd,吡嗪酰胺片0.5 g qd,盐酸乙酰丁醇片0.75 g qd四联抗结核治疗。经过治疗,患者生命体征相对稳定,意识状态仍较淡漠,3月29日转至专科医院继续抗结核治疗。

|
| 图 1 患者胸部CT征象 Fig. 1 Chest CT signs of the patient |

|
| 图 2 患者脑部CT征象 Fig. 2 Brain CT signs of the patient |

|
| 图 3 油镜下脑脊液抗酸染色结果 Fig. 3 Acid-fast staining of cerebrospinal fluid under oil microscope |
3月25日患者脑脊液涂片可见抗酸阳性杆菌,接种脑脊液于改良罗氏培养基,37 ℃培养3周后在培养基上可见黄色的菜花样菌落(见图 4),测序结果经BLAST比对为分枝杆菌属。分别送脑脊液及肺泡灌洗液进行结核分枝杆菌核酸定性检测(TB-DNA),结果均为阳性。3月26日,患者肺泡灌洗液宏基因组二代测序(metagenomic next-generation sequencing,mNGS)结果回报:结核分枝杆菌复合群(177)(见图 5)。脑脊液mNGS结果回报:结核分枝杆菌复合群(544)(见图 6)。结核感染T细胞γ干扰素(IFN-γ)释放试验结果为2.010 IU/mL↑。临床诊断为结核性脑膜炎继发性肺结核。
|
| 图 4 脑脊液培养3周结果 Fig. 4 Results of cerebrospinal fluid cultured for 3 weeks |

|
| 图 5 患者肺泡灌洗液mNGS结果 Fig. 5 mNGS results of bronchoalveolar lavage fluid of the patient |

|
| 图 6 患者脑脊液标本mNGS结果 Fig. 6 mNGS results of patient's cerebrospinal fluid specimens |
引起TBM的主要致病菌是结核分枝杆菌复合群(Mycobacterium tuberculosis complex, MTBC),它是一种需氧革兰氏阳性杆菌,抗酸染色阳性。2023年,分枝杆菌菌属有更新,MTBC更新后包含4个菌种,即卡内蒂分枝杆菌(M. canettii)、猫鼬分枝杆菌(M. mungi)、羚羊分枝杆菌(M. orygis)和结核分枝杆菌(M. tuberculosis)。以前的牛分枝杆菌、山羊分枝杆菌等5个菌种降级为结核分枝杆菌中不同宿主特异性的变种,即结核分枝杆菌非洲变种(variant africanum)、牛变种(variant bovis)、山羊变种(variant caprae)、田鼠变种(variant microti)和海豹变种(variant pinnipedii)[3]。
TBM患者脑脊液的特点是白细胞中度升高、蛋白升高、糖和氯化物降低等,TBM患者的脑脊液蛋白往往高于病毒性脑(膜)炎,中性粒细胞数则远低于细菌性脑膜炎[4]。本报道中,患者的脑脊液生化变化符合TBM患者的常规改变。有研究通过分析123例TBM患者资料后发现,分析TBM患者脑脊液相关参数对于鉴别TBM与其他颅内感染有较高的诊断价值[5]。本报道中,患者的结核感染T细胞升高,它的检测原理是机体感染MTB后,血液中的记忆性T淋巴细胞和单核细胞会在再次接触MTB时产生和分泌相应的细胞因子IFN-γ,从而使IFN-γ水平升高。结核感染T细胞IFN-γ释放试验诊断MTB感染的特异度以及与病理最终结果的符合度都很高[6],但IFN-γ的敏感性不高,若各种原因导致患者T细胞产生IFN-γ的能力降低,则结核感染T细胞IFN-γ释放试验的敏感性将随之降低[7]。
结核性脑膜炎常以非特异症状起病,包括头痛、发热、畏寒、乏力、精神萎靡、恶心、呕吐、食欲减退、体重下降等,以慢性及亚急性起病者居多[8]。脑膜刺激征、颅内压增高征象、癫痫、脑神经受累、肢体运动障碍等局灶性神经系统症状和体征均可出现。据英国医学研究委员会的分类方法,结核性脑膜炎的临床症状可分为以下3期[8](见表 1)。
| 分期 | 临床症状 |
| Ⅰ期 | 无特异性症状和体征、无意识模糊、无神经系统功能受损 |
| Ⅱ期 | 脑膜刺激征、轻度神经系统功能受损(如脑神经麻痹)、运动功能异常 |
| Ⅲ期 | 惊厥或抽搐、昏睡或昏迷、严重神经系统功能受损(如瘫痪或全身麻痹) |
本文中患者已出现意识淡漠的神经系统表现,入院后有昏迷表现,病情严重,已处于预后不良的Ⅲ期。临床上若能及时发现并诊治结核性脑膜炎患者,患者的治愈率将大大提高,且医疗支出也会降低。目前TBM的病原学诊断主要依靠脑脊液抗酸染色,即将脑脊液离心沉淀后行齐-内染色和金胺-罗丹明荧光染色,这是诊断中枢神经系统结核病最快速、简便的方法。临床应用中最为普遍的罗氏培养法,因分枝杆菌生长缓慢须4~8周才有结果,不利于早期诊断[9]。病原学分子检测技术——Xpert利用结核分枝杆菌核酸检测技术,能同时检测结核分枝杆菌的生长及利福平的耐药性[10]。一项研究表明,齐-内染色法、改良齐-内染色法、Xpert和结核菌培养的检验敏感度分别为33.9%、34.5%、25.1%和31.8%[11]。随着mNGS的不断发展与规范,这项技术在重症中枢神经系统感染中的应用越来越广泛,为疾病的精准诊断与治疗提供了实验室依据。
综上所述,脑脊液涂片染色法对TBM早期诊断很重要,但因对操作者的经验依赖性强、脑脊液菌载量低导致阳性率不足30%等因素,在临床实践中须构建阶梯式诊断体系:首选抗酸染色涂片进行初筛,对疑似病例联合应用分子检测(如Xpert MTB/RIF)及液体培养以提高确诊率。同时,临床医师须警惕TBM的“诊断窗口期”现象,即约20%患者首次脑脊液检测阴性,需间隔48~72 h重复采样;而检验工作者在临床工作中,对每一份脑脊液标本都应持审慎严谨的态度,谨防因疏忽而漏诊。
| [1] |
王乐乐, 郭建琼, 李俊刚, 杨松, 唐神结. 结核性脑膜炎治疗研究进展[J]. 中华临床感染病杂志, 2021, 14(5): 392-398. [DOI]
|
| [2] |
Donovan J, Thwaites G E, Huynh J. Tuberculous meningitis: where to from here?[J]. Current opinion in infectious diseases, 2020, 33(3): 259-266.
[DOI]
|
| [3] |
中国疾病预防控制中心传染病预防控制所, 中国防痨协会人兽共患结核病专业分会. 分枝杆菌菌种中文译名专家共识[J]. 中国人兽共患病学报, 2023, 39(3): 205-220. [DOI]
|
| [4] |
Schaller MA, Wicke F, Foerch C, Weidauer S. Central nervous system tuberculosis: etiology, clinical manifestations and neuroradiological features[J]. Clin Neuroradiol, 2019, 29(1): 3-18.
[DOI]
|
| [5] |
籍新潮, 万群, 兀瑞, 赵钢, 周林甫. 结核性脑膜炎123例临床分析[J]. 脑与神经疾病杂志, 2023, 31(3): 151-154. [URI]
|
| [6] |
徐宁, 郑瑞, 毛小琴, 撒亚莲. 结核γ—干扰素酶联免疫法释放试验结果及影响相关因素分析[J]. 中国实验诊断学, 2021, 25(1): 89-92. [DOI]
|
| [7] |
Cattamanchi A, Smith R, Steingart KR, Metcalfe JZ, Date A, Coleman C, Marston BJ, Huang L, Hopewell PC, Pai M. Interferon-gamma release assays for the diagnosis of latent tuberculosis infection in HIV-infected individuals: a systematic review and meta-analysis[J]. J Acquir Immune Defic Syndr, 2011, 56(3): 230-238.
[DOI]
|
| [8] |
徐勇明, 连世忠. 非典型结核性脑膜炎致高颅压一例报道[J]. 中华神经创伤外科电子杂志, 2017, 3(1): 54-56. [DOI]
|
| [9] |
中华医学会结核病学分会结核性脑膜炎专业委员会. 2019中国中枢神经系统结核病诊疗指南[J]. 中华传染病杂志, 2020, 38(7): 400-408. [DOI]
|
| [10] |
Bahr NC, Nuwagira E, Evans EE, Cresswell FV, Bystrom PV, Byamukama A, Bridge SC, Bangdiwala AS, Meya DB, Denkinger CM, Muzoora C, Boulware DR, ASTRO-CM Trial Team. Diagnostic accuracy of Xpert MTB/RIF Ultra for tuberculous meningitis in HIV-infected adults: a prospective cohort study[J]. Lancet Infect Dis, 2018, 18(1): 68-75.
[DOI]
|
| [11] |
Heemskerk AD, Donovan J, Thu DDA, Marais S, Chaidir L, Dung VTM, Centner CM, Ha VTN, Annisa J, Dian S, Bovijn L, Mai NTH, Phu NH, Chau NVV, Ganiem AR, Van CT, Geskus RB, Thuong NTT, Ruslami R, Meintjes G, van Crevel R, Wilkinson RJ, Thwaites GE. Improving the microbiological diagnosis of tuberculous meningitis: a prospective, international, multicentre comparison of conventional and modified Ziehl-Neelsen stain, GeneXpert, and culture of cerebrospinal fluid[J]. J Infect, 2018, 77(6): 509-515.
[DOI]
|
 2024, Vol. 19
2024, Vol. 19


